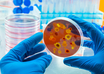

Study shows how diet quality affects gut microbiota to promote health
ANI | May 06, 2023
Study finds obesity as risk factor for colorectal cancer
ANI | May 05, 2023
Study reveals AI signals mirror how brain listens, learns
ANI | May 05, 2023
Doctors save preterm baby born without enough oxygen
IANS | May 05, 2023
Study finds no increased risk of menstrual changes after COVID vaccine
IANS | May 05, 2023
Low fat foods may prolong life, less carbs can raise death risk: Study
IANS | May 04, 2023
Surgical masks can help kids fight respiratory infections: Study
IANS | May 04, 2023
Dengue virus 'evolved dramatically' in India, is more severe: Study
IANS | May 04, 2023
Most read this week